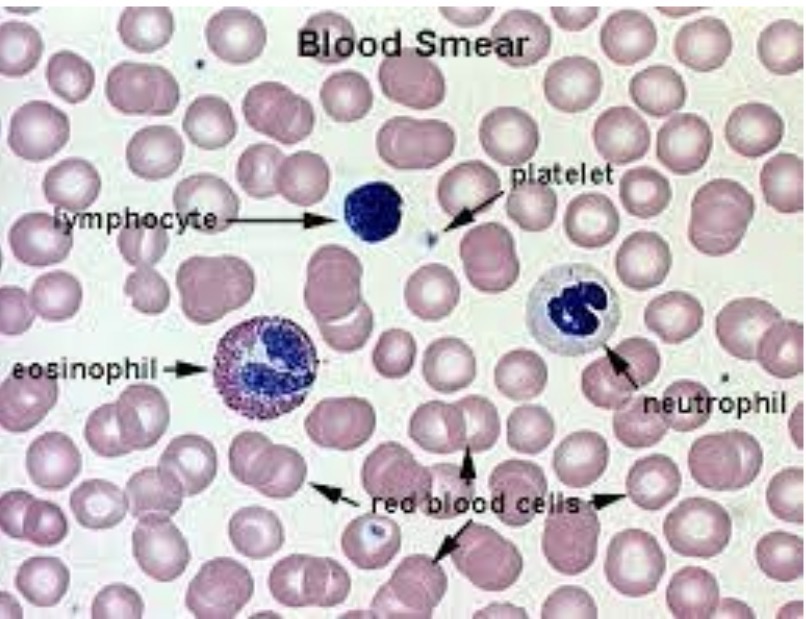

A + P Epithelial, Connective, Nerve and Muscle Tissu
1/107
There's no tags or description
Looks like no tags are added yet.
Name | Mastery | Learn | Test | Matching | Spaced |
|---|
No study sessions yet.
108 Terms

What class?
Epithelial

What type?
Simple Squamous

Where is this found?
air sacs of the lungs, capillaries

What is the function?
diffusion, filtration, secretion of serous flui

What class?
Epithelial

What type?
Stratified Squamous (non-keratinized)

What is the location?
lining of mouth, esophagus, vagina, anus

what is the function?
protection against abrasion, keeps surfaces moist

What class?
Epithelial

What type?
Simple Cubodial

What is the location?
kidney tubules, glands, ducts, surface of ovaries

what is the function?
secretion and absorption

What class?
Epithelial

What type?
transitional epithelium

what is the location?
urinary bladder, ureters, part of urethra

what is the function?
stretching and recoil, permits distension of urinary organ

what class?
epithelial

what type?
simple columnar (non-ciliated)

What is the location?
lining of digestive tract (stomach, intestines), gallbladder

what is the function?
absorption, secretion of mucus/enzymes

what class?
epithelial

what type
pseudostratified columnar (ciliated)

what is the location?
lining of trachea and most upper respiratory tract

what is the function?
secretion (especially mucus) and propulsion of mucus by ciliary action

what class?
epithelial

what type?
simple columnar (ciliated)

what is the location?
lining of uterine tubes, small bronchi

what is the function?
movement of substances (egg in uterine tube, mucus in bronchi)

what class?
epithelial

what type?
stratified squamous (keratizined)

what is the location?
epidermis of skin

what is the function
protection against abrasion, pathogens, water loss

what class?
epithelial

what type?
stratified cubodial

what is the location?
ducts of sweat glands, mammary glands, salivary glands

what is the function?
protection, secretion

what class?
epithelial

what type?
stratified columnar

what is the location?
rare; male urethra, large ducts of some glands

what is a the function?
secretion

what class?
connectice

what type?
areolar (loose)

what is the location?
under epithelia, around capillaries, packages organs

what is the function?
wraps and cushions organs; holds tissue organs

what class?
connective

what type?
adipose

what is the location?
subcutaneous tissue, around kidneys, breasts, abdomen

what is the function?
energy storage, insulation, cushioning

what is the class?
connective

what type?
dense regular

what is the location?
tendons, ligaments, aponeuroses

what is the function?
withstands stress in one direction, strong attachment

what class?
connective

what type?
dense irregular

what is the location?
dermis of skin, fibrous capsules of joints and organs

what is the function?
withstands tension from multiple directions

what class?
connective

what type?
reticular

what is the location?
lymph nodes, spleen, bone marrow

what is the function?
supports framework for soft organs
what class?
connective

what type?
blood

what is the location?
within blood vessels and heart

what is the function?
transports gases, nutrients, wastes; immune defense; clotting

what class?
connective

what type?
bone

what is the location?
skeleton (bones)

what is the function?
support, protection, movement, stores calcium, blood cell production

what class?
connective

what type?
hyaline cartilage

what is the location?
nose, trachea, larynx, costal cartilage, ends of long bones

what is the function?
support, flexibility, smooth surface for joints

what class?
connective

what type?
fibrocartilage

what is the location?
intervertebral discs, pubic symphysis, menisci of knee
whata is the function?
absorbs compressive shock

what class?
connective

what type?
elastic cartilage

what is the location?
external ear, epiglottis

what is the function?
strength + flexibility

what class?
connective

what type?
elastic connective

what is the location?
walls of large arteries, bronchial tubes, ligaments of vertebral column

what is the function?
allows recoil snd stretching

what class?
connective

what type?
lymph

what is the location?
lymphatic vessels, lymphoid organs

what is the function?
returns interstitial fluid to blood, immune surveillance

what class?
nerve

what type?
multipolar neuron

what is tbe location?
brain, spinal cord, motor neurons to skeletal muscles

what is the function?
integrates and transmits impulses to other neurons or effectors

what class?
neurolgia

what type?
astrocytes

what is the location?
CNS (brain + spinal cord)

what is the function?
support, from blood-brain barrier, regulates nutrients + ion balance, repair tiasue

what class?
muscle

what type?
skeletal muscle cell (fiber)

what is the location?
attached to bones via tendons

what is the function?
voluntary movement of body, posture, heat production